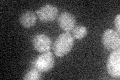

View description
Ubiquitin-protein ligase required for endoplasmic reticulum-associated degradation (ERAD) of misfolded proteins; genetically linked to the unfolded protein response (UPR); regulated through association with Hrd3p; contains an H2 ring finger
Localization:
Intensity:
Fold change:
Significance:
-
C’ GFP library in SD
ER21.46 -
N' NOP1pr-GFP in SD

N/A0 -
N' TEF2pr-mCherry in SD

N/A0 -
N' NATIVEpr-GFP in SD

N/A0 -
N' TEF2pr-VC and Cyto-VN in SD

N/A0 -
C’ GFP library in SD+DTT

ER30.661.42Yes -
C’ GFP library in SD+H2O2

ER22.611.05No -
C’ GFP library in Starvation Media

ER26.981.25No -
C’ GFP library on the background of Pup2-DaMP

ER -
C’ GFP library on the background of CCT mutant

ER16.50650.76901No
